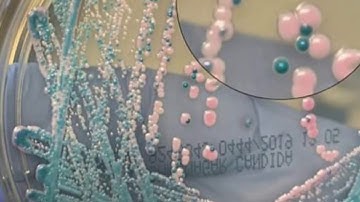

⬇ DOWNLOAD NOW
Kalau muncul iklan pop-up, tutup lalu klik tombol kembali
Download lagu Candida tropicalis fermentation using advanced fed-batch algorithm secara gratis hanya untuk keperluan promosi. Dukung artis favorit kamu dengan membeli musik original di iTunes atau platform resmi lainnya.
Colonias de Cándida Tropicalis
Colonias de Cándida Tropicalis
 Fed-Batch Fermentation
Fed-Batch Fermentation
 Fed-batch microbial fermentations
Fed-batch microbial fermentations
 Candida tropicalis
Candida tropicalis
 Sacharomyces cerevisiae fed-batch fermentations using bioreactors EDF-5.3.1
Sacharomyces cerevisiae fed-batch fermentations using bioreactors EDF-5.3.1
 continuous fermentation
continuous fermentation
 What Is Candida Tropicalis?
What Is Candida Tropicalis?
 Control algorithms and strategies of feeding for fed-batch fermentation of Escherichia coli
Control algorithms and strategies of feeding for fed-batch fermentation of Escherichia coli